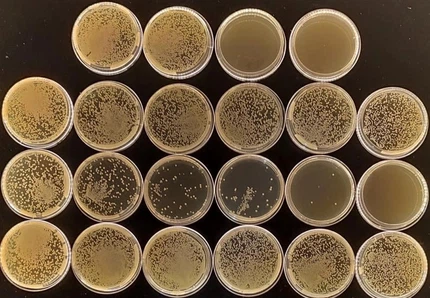
Iodine Balls CAS 12190-71-5 | Shaanxi BLOOM Tech Co., Ltd Iodine Balls CAS 12190-71-5 | Shaanxi BLOOM Tech Co., Ltd

Jodové kuličky,zprvu známé jako krásné zvláštnosti se nyní změnily v doménu úpravy a dekontaminace vody kvůli rostoucímu důrazu na čistou pitnou vodu. Tyto malé kroužky vzbudily zvědavost a zájem o jejich možné výhody při zaručení bezpečného využívání vody. V tomto článku se ponoříme do složitosti kuliček – podíváme se na jejich syntézu, užitečnost a aplikace při čištění vody. Využitím zkušeností z pevných zdrojů plánujeme odhalit vhled do přiměřenosti a flexibilityjodové kuličkyv obavách o kvalitu vody. Jak se ukazuje, že si společnost více uvědomuje význam přístupu ke konzumní vodě, zkoumání kreativních uspořádání, jako jsou koule, zdůrazňuje naši povinnost chránit obecný blahobyt a prosperitu. Vydejte se s námi na exkurzi odhalit tajemství za koulemi a zjistěte, jak by mohly změnit scénu inovací v oblasti čištění vody.
Co jsou jódové kuličky?
Jodové kuličkyjsou kulaté předměty obsahující jód, flexibilní sloučeninu, která se vyznačuje silnými dezinfekčními vlastnostmi. Tyto konzervativní koule zaujímají stěžejní roli v prostoru úpravy a čištění vody tím, že skutečně bojují s nebezpečnými mikroorganismy a mikroby, které by se mohly potulovat ve vodních zdrojích, a tím je dodávají rozumné pro lidské využití. Jód, výjimečně silný specialista na dezinfekci, prokazuje významnou životaschopnost při eliminaci různého spektra mikroorganismů, infekcí a prvoků a následně zásadním způsobem zmírňuje převahu vodou přenášených nemocí, které představují nebezpečí pro celkový blahobyt.
V okamžiku, kdy jsou kuličky vneseny do vody, začnou kontinuální proces dezintegrace, při kterém je jód obsažený uvnitř kruhů dodáván jako částice jódu. Tyto částice se účinně účastní sterilizačního cyklu a uplatňují své antimikrobiální vlastnosti k dezinfekci vody a odstranění pravděpodobných nečistot. Tento náročný sanitační nástroj zaručuje, že upravená voda splňuje přísné bezpečnostní směrnice a kupujícím zaručuje její neposkvrněnost a přiměřenost pro konečný cíl pití.
Flexibilita a snadné použitíjodové kuličkyaby byly funkční a užitečnou odpovědí na dekontaminaci vody v různých prostředích. Ať už jsou používány při venkovních sportovních cvičeních, například při stavění tábora, nebo jsou posílány v krizových situacích, kdy je omezen přístup k čisté pitné vodě, míče vznikají jako pevné zařízení pro ochranu kvality vody. Jejich menší plán a pohodlí zvyšují jejich přitažlivost jako vhodná volba pro úpravu vody, kterou lze okamžitě využít k řešení měnících se potřeb sanitace.
Jak jódové kuličky pomáhají při čištění vody?
S ohledem na vzory lovu zaznamenané na kontejneru Google Dross Skim Container,jodové kuličkyse staly předmětem rostoucího zájmu kvůli jejich slibným aplikacím při čištění vody. Hlavní složkou je progresivní disperze jódu do vody, cyklus, který má možnost skutečně bojovat s mikroby, infekcemi a různými mikroorganismy, které mohou být ve vodním zdroji dostupné. Tento cílevědomý příchod jódu se plní jako základní metodika sterilizace, která přispívá k vytváření bezpečnější a konzumovatelnější vody pro využití.
Adaptabilita a životaschopnost kuliček v situacích filtrace vody jsou zvláště významné v podmínkách, kde je nutný nebo ohrožený přístup k čisté vodě. Například lidé, kteří se účastní venkovních cvičení, jako je zakládání tábora, mohou těžit z ubytování a neochvějné kvalityjodové kuličkyupravovat vodu z běžných zdrojů a zaručit její blahobyt. Podobně v krizových situacích popsaných narušenými dodávkami vody nebo katastrofickými událostmi nabízejí tyto zmenšené kruhy důležitou výhodu pro rychlé čištění vody a zmírnění hazardních her souvisejících se znečištěnou vodou.
Jsou jódové kuličky účinné proti bakteriální kontaminaci?
Přiměřenostjodové kuličkyv boji proti bakteriální nečistotě nashromáždila pozornost v oblasti úpravy vody. Jód, vnímaný pro své antimikrobiální vlastnosti, uplatňuje svou dezinfekční aktivitu tím, že narušuje buněčné stěny a filmy mikrobů při dodání do vody. V každém případě se objevují obavy ohledně dostatečného množství fixace jódu uvolněného kuličkami k úspěšnému ošetření významných objemů vody. Výzkum ukazuje, že zatímco kuličky vykazují schopnost snižovat bakteriální hladiny, jejich životaschopnost nemusí odpovídat tomu, jak se blíží elektivní úprava vody, jako je bublání nebo používání tablet na čištění vody. Tyto blízké vyšetření doporučují, že zatímcojodové kuličkymají záruku snížení bakteriálního znečištění, jejich prezentace může být překonána různými technikami známými pro jejich sílu při provádění rozsáhlého čištění vody. V této funkci zůstává naléhavé další zkoumání a přemýšlení o různých možnostech úpravy vody při snaze o vícevrstevnou výzvu bakteriálního znečištění vodních zdrojů.
Mohou jódové kuličky nahradit tradiční metody úpravy vody?
Otázka zdajodové kuličkymůže fungovat jako náhražka obvyklých strategií úpravy vody představuje vícevrstvý problém. Navzdory jejich výhodám v poskytování základní a praktické strategie pro filtraci vody může být jejich vhodnost ve specifických situacích omezena. Je pozoruhodné, že kuličky nemusí nabízet životaschopnost proti explicitním mikroskopickým kmenům organismů, jako je Cryptosporidium, které je známé svou ochranou před ošetřením jódem. Kromě toho složka ustáleného vypouštění jódu může vykazovat nedostatek ve výskytu výjimečně znečištěné vody nebo tam, kde je vyžadována předvídatelná úroveň sanitace. Tyto proměnné zvýrazňují nuanční úvahy zabývající se posuzováním možnosti záviset výhradně najodové kuličkyjako důkladná odpověď na úpravu vody s významem posouzení jejich výhod a překážek proti konkrétním požadavkům a obtížím za všech okolností.
Závěr
Jodové kuličkypředstavují fascinující a nápaditou cestu pro zušlechťování vody, která nabízí užitečnou a latentní metodu sterilizace. Zatímco jejich potenciální výhody jsou jasné, téma jejich životaschopnosti a vhodnosti jako základní strategie úpravy vody zůstává předmětem neustálé diskuse. Je důležité pečlivě zhodnotit současné výjimečné potřeby a podmínky při zvažování využití kuliček oproti rozmístěným a předvedeným obvyklým technikám úpravy vody. Faktory, jako je myšlenka cizích látek, pokyny pro kvalitu vody a běžnost explicitních mikrobů, by měly být zváženy, aby se hodily k erudovanému výběru. Konečně, vyčerpávající způsob, jak se vypořádat s úpravou vody, může zahrnovat kombinaci různých metod přizpůsobených konkrétním potřebám a obtížím za všech okolností, které zaručují uspořádání chráněné a konzumovatelné vody pro všechny.
Reference
1. "Zdravotní přínosy a využití jódu." Verywell Health, Heidi Moawad, MD, aktualizováno 24. května 2023.
2. "Jód - Informační list pro zdravotníky." Úřad pro doplňky stravy, National Institutes of Health, přístupný 25. února 2024.
3. "Jód|Chemické vlastnosti, použití a aplikace." Britannica, přístup 25. února 2024.
4. "Komplexní zpracování hliníkové strusky v Číně: Kritický přehled." ScienceDirect, přístup 25. února 2024.
5. "Implementace komplexního managementu odpadů." Springer, přístup 25. února 2024.

